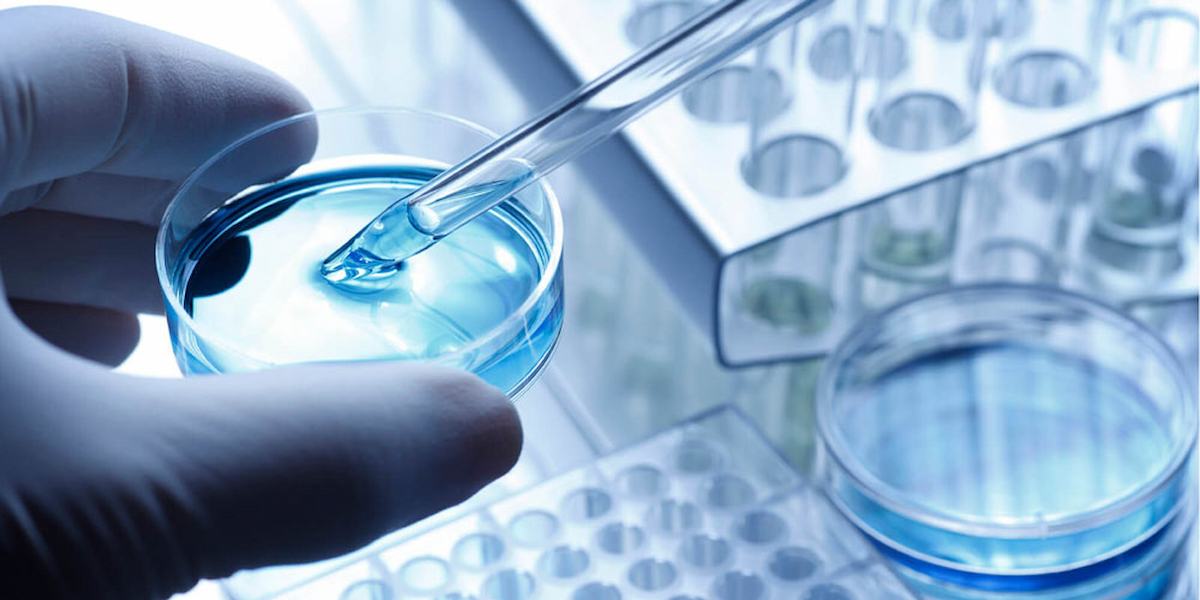

یکی از مباحث مهم در این مقاله آب مقطر دیونیزه در اصفهان تبریز است همواره آب به عنوان مایه حیات در دست بشر بوده و از آن در مصارف گوناگون همانند آب مقطر پزشکی استفاده میکرده است شکل گیری تمدن های ابتدایی در سراسر جهان در کنار رودخانه ها و دریاچه های که آب شیرین و قابل مصرف داشتن پدید آمده و از آنجا تمدن شروع شده و در آخر به کل جهان سرایت کرده است.
بشر همواره از آب در مصارف گوناگون استفاده کرده است که میتوان از جمله آن به استفاده در کشاورزی و یا صنعت اشاره کرد مقدار آب که در کشاورزی استفاده می شود حجم قابل توجهی بوده که اخیراً با توجه به مکانیزه کردن دستگاه های کشاورزی و آبیاریهای قطره ای از طریق نوار تیپ قطره ای توانستند مقدار آب مصرفی و حجم آن را کاهش دهند و در مصرف آب به عنوان یک مایع حیاتی برای کل بشریت از صرفه جویی برابرند.
فروش اب دیونیزه در اصفهان
در این گفتگو و مطلب در خصوص فروش آب دیونیزه در اصفهان صحبت می کنیم اگر بخواهید فرق و تفاوت بین آب مقطر و آب دیونیزه را دقیقاً بدانید باید به این نکته اشاره کنیم که روش تصفیه اب مقطر فوق خالص به عنوان یکی از قدیمی ترین روشهای تصفیه آب می باشد ولی آب دیونیزه را با استفاده از روشهای جدید و مدرن تصفیه می کنند ضمن اینکه آب دیونیزه بسیار درجه خلوص بالاتری نسبت به آب مقطر دارد.
البته لازم به ذکر است که روش تصفیه آب به شیوه دیونیزاسیون بسیار ارزان تر از روش تقطیر آب به شیوه قدیمی تر آن می باشد، به نظر ذکر این نکته خالی از لطف نباشد که در تقطیر آب و ایجاد آب مقطر آلودگیها و ناخالصیها از آب جدا میشود و یونها و مواد معدنی همچنان در آب باقی ماند اما در آب دیونیزه در واقع یونها و مواد معدنی و املاح آب از آنها جدا میشوند و ترکیبات عالی و مواد آلی و معدنی آب نیز جدا شده و تصفیه انجام می گردد.
آب مقطر دیونیزه در اصفهان
همانطور که گفته شد در خصوص آب مقطر دیونیزه در اصفهان یا مطلق آب دیونیزه لازم به ذکر است به دلیل عدم وجود املاح و مواد معدنی در خود می تواند آب مناسبی برای پرورش ماهی در استخرهای ماهی و به عنوان ذخیره در تانکرهای مربوط به تامین آب استخرهای ماهی باشد چرا که به دلیل فقدان مواد معدنی از جلبک بستن کنار استخرها جلوگیری به عمل می آید و آب خالصی می باشد که در این زمینه کاربردهای بسیار خوبی دارد.
به دلیل خلوص بسیار زیادی که آب دیونیزه دارد از این آب می توان در ساخت و تولید محصولات آرایشی بهداشتی و لوسیونهای بهداشتی استفاده کنند چرا که خلوص این آب باعث خواهد شد از انواع باکتریها و یا آلودگیها که منجر به انتقال بیماری به پوست میشود جلوگیری به عمل آید به همین دلیل کاربردهای بسیار زیادی در ساخت لوازم آرایشی و بهداشتی دارند.
در واقع بشر توانست در طی سالها مجاورتی که با رودخانه ها و دریاچه ها به عنوان خاستگاه تمدن بشری داشته کم کم آب را به منازل خود هدایت کند و ابتدا برای این کار از لوله هایی که از طریق سفالهایی همانند کوزه استفاده می شده است
در دل کوه و طبیعت لوله کشی کرد و آن را به داخل منازل خود رساند و بعدها توانست با اختراع و ایجاد لوله های آهنی، فلزی یا پلاستیکی آب را به داخل منازل خود هدایت کنند اما همواره سوء مصرف و اسراف در این زمینه باعث است که مشکلاتی نظیر قحطی آب دامن بعضی از کشورها نظیر ایران را بگیرد.
آب دیونیزه تبریز
در ادامه مطالب خود به کارایی و مزایای استفاده از آب دیونیزه تبریز آب دیونیزه تبریز می پردازیم کارایی که این محصول در زندگی امروزه دارد اشاره خواهیم کرد در واقع آب دیونیزه به دلیل عدم وجود یونهایی که نام برده شد مانند یک جاذبه در جذب یونهای دیگر عمل میکند.
در واقع شما می توانید به دلیل عدم وجود یونها در آب دیونیزه و دلیلی که در بالا گفته شد از آن به عنوان ماده پاک کننده بسیار تمیز و خوب در پاک کردن چوبها و یا آینه دکوراتیو و یا سطوح دیگر در خانه یا محل کار خودتان استفاده نمایید
چرا که هیچ اثری از خود به جا نمی گذارد و آنها را بسیار پاک و تمیز می کند و یک محلول تمیز کننده عالی برای از بین بردن مواد شیمیایی و بقایای اجسام ریزی است که به سطوح صاف و غیره چسبیده است.
آب دیونیزه در مشهد
در رابطه با انواع و اقسام آب دیونیزه و نیز آب دیونیزه در مشهد قبل از هرچیز در این مقاله صحبت می کنیم اما خوب است بدانید معمولاً آبهای لوله کشی سرشار از کلسیم و آهن و مس می باشند در واقع وجود این مقدار از یونهای مانند مس و آهن و کلسیم در آبهای لوله کشی به دلیل خاکی است که این آب از آنجا برآمده است یا به دلیل لوله های فلزی یا مسی می باشد که مسیر انتقال آب به منازل شما است.
آب دیونیزه در واقع آبی است که فاقد املاح و مواد معدنی و یونهایی که برای بدن مورد نیاز هست می باشد و اگر بخواهیم آب را در یک تقسیم بندی کلی به دسته بندی و به اقسام آن اشاره کنیم می توانیم آب را به چند نوع آب تصفیه شده، آب دیونیزه و یا آب قلیایی اشاره کنیم.

آب دیونیزه شیراز
در این این جستار نسبت به آب دیونیزه شیراز صحبت می کنیم آب دیونیزه یا آب مقطر در واقع آبی است که فاقد هرگونه از املاح معدنی می باشد در واقع یونهای که در آب معمولی وجود دارد در این نوع آب کاملاً حذف شدند در واقع آبهای لوله کشی که سرشار از مواد عالی، کانیها و یونهایی هستند که برای بدن انسان نیازمی باشد که از محیط طبیعی به منازل شما از طریق لوله کشی منتقل می شوند
اگر بخواهیم تعریفی دقیق و مملوس به ذهن از یونها ارائه دهیم می توانیم آنها را در دسته های مختلفی شاخه بندی کنیم بخشی از یونها شامل یونهای هستند که شامل عنصر کلسیم را برای برطرف کردن نیاز به شما به کلسیم در خود دارند همچنین می توانیم به یون آهن یا سدیم نیر اشاره کنیم.

اکنون که شما توانستید در این مطلب نسبت به مزایای آب دیونیزه و نیز کاربردهای آن آشنا شوید و همچنین تفاوتهای بین آب دیونیزه و آب مقطر و سایر آبها را شناخت پیدا کنید شما عزیزان می توانید با مراجعه به سایت ما در این خصوص و کاربردهای بیشتری که آب دیونیزه دارد اطلاعات خودتان را افزایش دهید و در این رابطه تحقیق نمایید.
همچنین شما بزرگواران می توانید در صورتی که در این زمینه سولاتی داشته باشید از طریق ارتباط گرفتن با مشاوران ما آن را مطرح کنید و پاسخ خودتان را دریافت نمایید و از طریق سایت ما خریدی خوب و مطمئن را نسبت به کیفیت این محصول و نیز قیمت مناسب آن نسبت به بازار و رقابتی بودن آن تجربه نمایید و سفارش خرید دهید.